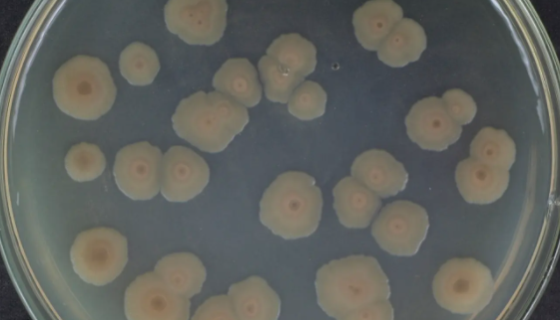
芽孢杆菌对水质净化的作用机理及作用效果！
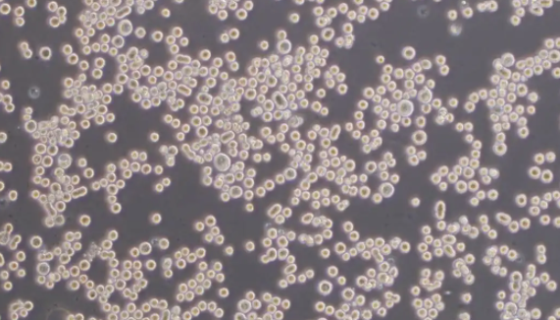
人T淋巴细胞系的性质、用途与生产工艺！

SKNO-1细胞培养实验操作规程!
细胞操作步骤及说明

REC-1人套细胞淋巴瘤细胞的培养实验操作规程!
人套细胞淋巴瘤细胞,仅用于科研工作,未经许可不得用于其他目的...

嗜松青霉的生物特性与培养条件及注意事项!
嗜松青霉,本种的质地主要呈现絮状,37℃培养时生长发青良好,...

C-9 人肺癌细胞接收后的处理方法与培养步骤!
人肺癌细胞来源于人类腺癌的肺组织,至今仍有分化。仅用于科学研...
芽孢杆菌对水质净化的作用机理及作用效果!
芽孢杆菌作为一种简易的细菌(真细菌),是土壤中的优势种群,能...

小鼠胚胎干细胞R1收到后的处理方法与培养步骤!
小鼠胚胎干细胞R1仅用于科学研究或者工业应用等非医疗目的不可...

人风湿性关节滑膜成纤维细胞永生化的操作步骤!
人风湿性关节滑膜成纤维细胞的传代与复苏及冻存操作步骤。
人T淋巴细胞系的性质、用途与生产工艺!
人T淋巴细胞系是HUT78(ATCCTIB161)的克隆系(...

人急性髓系白血病细胞接收后的操作流程与注意事项!
人急性髓系白血病细胞仅用于科学研究或者工业应用等非医疗目的不...